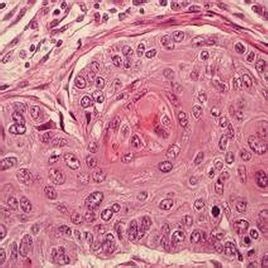
磷癌 磷癌

簡介
磷癌有:肺磷癌、陰道磷癌、食道磷癌、宮頸磷癌等。
磷癌是來源於支氣管上皮的一種惡性上皮性腫瘤,可表現角化和/或細胞間橋特徵。包括梭形細胞癌,是最常見的類型,約占原發性肺癌的35%-45%。
磷癌一般認為與環境有關,尤其是陽光的刺激有明顯關係,長期日光曬曝和慢性刺激是主要發病潛因,外傷、放射線照射、焦油類衍生物亦可誘發本病,盤狀紅斑狼瘡、慢性潰瘍、黏膜白斑、燒傷瘀痕及長期不愈的肉腫均可誘發磷狀細胞癌。
症狀
磷癌約占皮膚癌的90%左右。磷癌30~50歲年齡多發。往往由角化病、黏膜白斑及其它癌前疾病轉化而成。磷癌初起為暗紅色,質硬,高於皮面的結節,以後表面的角質層脫落出現紅色的糜爛面,伴有滲血、滲液,病灶漸漸擴大。磷癌生長較快,早期即形成潰瘍。有的呈結節樣或菜花狀,向深部侵犯較小,基底可移動;有的呈蝶狀,向深部浸潤較明顯,破壞性大,常累及骨骼。磷癌常伴有化膿性感染,伴惡臭、疼痛。多見區域性淋巴結轉移,巨大磷癌,其惡臭無比,膿性分泌物較多,易出血;發生頸部淋巴結轉移。磷癌發病部位以黏膜皮膚連線處磷狀細胞癌發展最快,黏膜發病者更容易轉移。
磷癌大部分發生在慢性潰瘍、黏膜白斑、著色性乾皮病等基礎上。好發部位為眼瞼、鼻、唇、顳、頰、額、四肢,包皮、龜頭、軀幹也可發生。與基底細胞癌相比,磷癌發展較快,易出現轉移。據統計,下肢皮膚癌發生轉移的較多,其次為手背部和面 頸部,血行轉移罕見,肺臟為最常見的轉移臟器。基底細胞癌損害發展緩慢,一般極少發生區域性淋巴結轉移,也無遠處轉移。
皮膚磷癌是皮膚腫瘤中常見的類型,其發病率僅次於皮膚基底細胞癌。纖維連線蛋白(fibronectin,FN)是人骨髓長期培養體系LTBM細胞中分離出來的一種大分子多功能的細胞外基質(extracellular matrix,ECM)糖蛋白,可以連線多種細胞、生長因子及其他ECM成分,可以吸引趨化巨噬細胞,發揮非特異性調理素作用,利於巨噬細胞(Mφ)、淋巴細胞(Lc)與癌細胞在局部發揮細胞毒效應。FN與細胞內肌動蛋白微絲空間關係存在一種“跨膜協同聯繫”(coordinated transmembrane association),在轉化細胞中發揮了與細胞運動功能有關的作用[1,2]。本文研究50例皮膚磷癌(SSC)中癌細胞生物學行為及間質Mφ、Lc反應與癌中FN改變的關係。